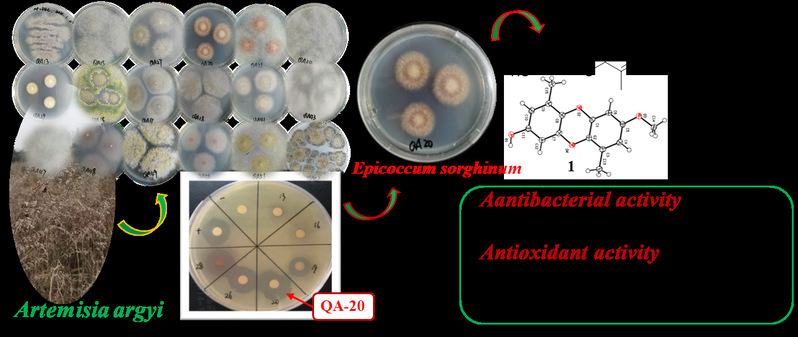

近日,重点实验室石小杉博士在国际农林科学领域期刊《Industrial Crops & Products》(中科院1区TOP)上发表研究论文。重点实验室为第一通讯单位,23级研究生刘淼为第一作者,24级研究生江棋乐为第二作者,石小杉博士与夏险博士为共同通讯作者。

艾(Artemisia argyi)是我国传统药用植物,蕲春“蕲艾”更为国家地理标志性产品,具有重要的药用与经济价值。本研究从蕲艾中共分离获得40株内生真菌,经过发酵筛选,发现一株内生真菌——高粱附球菌Epicoccum sorghum QA-20对多株水产病原菌具有显著的抑制活性,通过大规模发酵,色谱分离和波谱技术,共从中分离鉴定出1个结构新颖的聚酮类化合物以及12个已知化合物,新化合物通过X-射线单晶衍射确定了其绝对构型。在生物活性测试中,化合物6对全部7种测试水产病原菌均表现出抑制效果(MIC = 12.5–100 μg/mL),显示出广谱抗菌潜力,化合物7则具有与维生素C相当的抗氧化能力。该研究从蕲艾内生真菌中发掘出兼具抗菌与抗氧化活性的天然产物,为开发绿色病害防控制剂与天然抗氧化剂提供了新的候选分子与资源依据。
上述研究获得以下基金项目资助:国家自然科学基金项目(32100320),湖北省自然科学基金项目(2022CFB503,2025AFD008),湖北省教育厅科学研究计划重点项目(D20242504),以及湖北省中央引导地方科技发展专项(2025CSA104)。(审核 李刚华)
论文链接:https://doi.org/10.1016/j.indcrop.2026.122751

